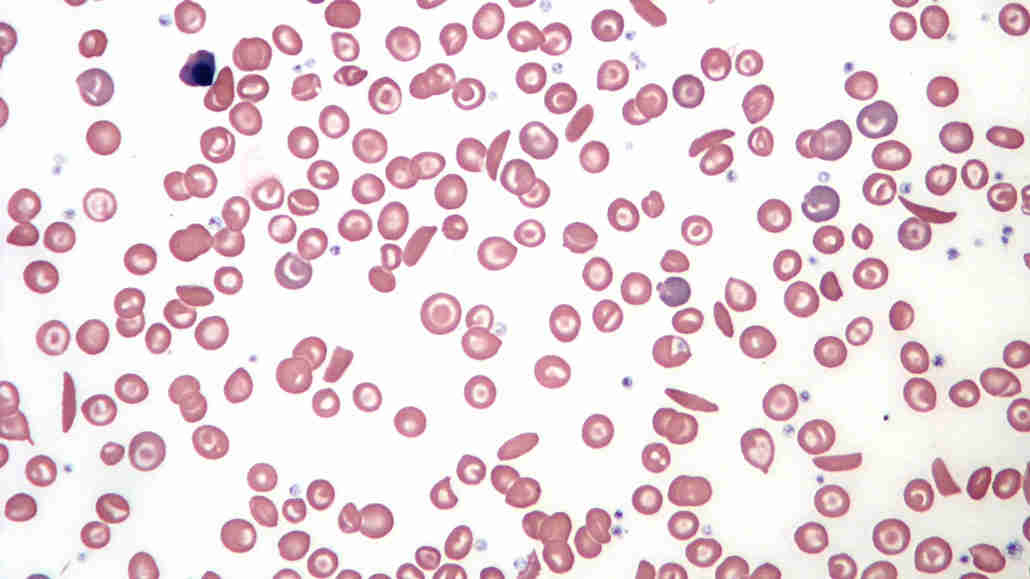

时间:2022-06-06 10:58:07来源:
尿素标准化细胞 - 科学新闻,1970年12月19日
尿素静脉注射现在似乎承诺成功治疗镰状细胞患者。...尿素导致镰状细胞恢复到正常的甜甜圈形状。到目前为止,尿素的静脉注射输注在测试的22名患者中释放了镰状细胞危机。
镰状细胞疾病导致痛苦的凝块,可以导致中风和损伤器官。骨髓移植,始于20世纪80年代为镰状细胞患者,是一种治疗,但寻找捐赠者可能是挑战性的。1998年,致羟基脲的尿素基化合物成为美国食品和药物管理局批准的第一种药物治疗镰状细胞疾病的药物。直到那时,没有移植,医生只能缓解止痛药和输血的症状。
羟基脲仍然被使用。因为该化合物可以高剂量毒性,因此科学家们继续寻找更好的治疗方法。在美国正在使用的临床试验正在使用基因编辑工具CRISPR / CAS9来编辑镰状细胞患者的DNA,以努力击败疾病(SN:8/31/19,p。 6)。
声明:文章仅代表原作者观点,不代表本站立场;如有侵权、违规,可直接反馈本站,我们将会作修改或删除处理。
图文推荐
2022-06-06 10:58:03
2022-06-06 09:58:05
2022-06-06 09:49:36
2022-06-06 09:48:13
2022-06-06 09:46:58
2022-06-06 09:46:11
热点排行
精彩文章
2022-06-06 10:58:05
2022-06-06 10:10:42
2022-06-06 10:09:52
2022-06-06 10:08:54
2022-06-06 10:08:16
2022-06-06 10:07:32
热门推荐